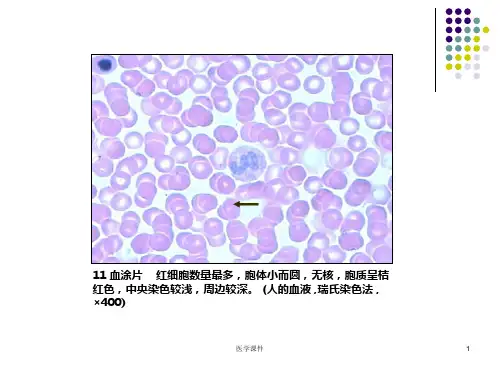

医学课件
5
70 透明软骨 软骨膜位于软骨表面,由致密结缔组织构成,与周围的结 缔组织相延续,因而界限不很清楚。软骨膜分内、外两层,外层胶原纤 维多,细胞少;内层纤维少,细胞较多,其中含有一些体积小,呈梭形 的骨祖细胞。 (人的气管 , HE, ×100)
医学课件
6
70 透明软骨 软骨基质中,硫酸软骨素的含量较多,呈强嗜碱性,被染成深蓝色, 形似囊状包围软骨细胞,此区域称软骨囊。 (人的气管 , HE, ×400)
医学课件
23
26 大脑 : 观察锥体细胞 锥体细胞大小不,形态类似。胞体呈锥体形,自顶端发出
粗大的主树突走向皮质表面,沿途发出许多小分支,胞体还向四周发出一些水平走向的树
突,所有树突上均有棘刺。自胞体底部发出一支细长、光滑的轴突,长短不一,长者走向
髓质,但常被切断(猫,COX法染色,左×100,中、右×400)
Z线明显) 。(兔的腓肠肌 , HE,×400)
医学课件
13
16 心肌 纵断面: 心肌纤维短柱状,有分支;有横纹,但不如骨骼肌清晰;细 胞核一个或两个,椭圆形,位于中央。相邻心肌纤维之间有闰盘。心肌纤维之间 有少量结缔组织和丰富的毛细血管。 (羊的心脏 ,HE,×100)
医学课件
14
示教 心肌纵断面: 心肌纤维短柱状,有分支;有横纹,但不如骨骼肌清晰;
医学课件
16
20 多极神经元: 五个体积大,多突起的细胞,为多极神经元。体积较小的胞核为 神经胶质细胞核。(猫的脊髓 ,甲苯胺兰染色 , × 200)
医学课件
17
22 有髓神经纤维 纵断面: 神经纤维平行排列,之间有少量结缔组织。神经纤维的中
央的紫红色的线状结构为轴突。轴突的两侧,染色较淡,呈细网状的为髓鞘。髓鞘两侧